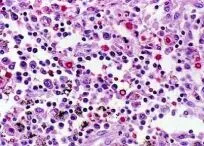

COLLOIDAL SILVER

COLLOIDAL SILVER YOUR IMMUNE SYSTEM'S BEST FRIEND PRODUCE YOUR OWN COLLOIDAL SILVER
AT NO COST PROTECT AND IMPROVE THE HEALTH
OF YOUR FAMILY, FRIENDS,
ALWAYS HAVE A RELIABLE, FRESH SOURCE AT YOUR FINGERTIPS, ANYTIME, ANYWHERE, FOR YEARS. IT IS QUICK : IT IS EASY TO OPERATE: YOU WILL GET YEARS OF USE:
Early Research The Food and Drug Administration today classifies colloidal silver as a pre-1938 drug. A letter from the FDA dated 9/13/91 states: "These products may continue to be marketed . . . as long as they are advertised and labeled for the same use as in 1938 and as long as they are manufactured in the original manner." Some of the manufacturing methods used before 1938 are still used today. An electro-colloidal process, which is known to be the best method, is used. Contemporary Studies |
How It Works Product Quality Ingesting Colloidal Silver Chronic or Serious Conditions In cases of illness, natural health practitioners have often recommended taking double or triple the "nutritional amount" for 30 to 45 days, then dropping down to a smaller maintenance dose. Amounts from 1 - 32 ounces per day have reportedly been used in acute conditions. If your body is extremely ill or toxic, do not be in a hurry to clear up everything at once. If pathogens are killed off too quickly, the body's five eliminatory channels (liver, kidneys, skin, lungs and bowel) may be temporarily overloaded, causing flu-like conditions, headache, extreme fatigue, dizziness, nausea or aching muscles. Ease off on the colloidal silver to a smaller amount and increase your distilled water intake. Regular bowel movements are a must in order to relieve the discomforts of detoxification. Resolve to reduce sugar and saturated fats from the diet, and exercise more. Given the opportunity, the body's natural ability to heal may amaze you. Topical Uses
Some Common Uses of Colloidal Silver
Tolerance To Disease Organisms
Additionally, there has never been a drug interaction reported between colloidal silver and any other medication. It's difficult to overdose - unless large amounts are ingested. Colloidal silver has been reported by users to be both a remedy and a prevention for numerous infections, colds, flus, and fermentations due to various bacteria, viruses or fungi, even the non-apparent low-grade, general body infections many people have. Living organisms are in the colloidal chemical state, not the crystalline state. Substances already in that form may be more readily assimilated by the body. Colloidal silver is the most useable form of a reputedly effective germ fighter. A colloidal suspension is ultra-fine particles of one substance, suspended by an electric charge in another substance. Homogenized milk and aerosol sprays are colloidal suspensions. Colloidal silver is pure, metallic silver (not a chemical compound) of particles 15 atoms or fewer, each with a positive electric charge, and attached to a molecule of simple protein. This new particle floats in pure water. The electric charge is stronger than gravity so the silver particles don't sink. Colloidal Silver in Advance of Illness? Older folks reportedly feel younger because their body energies are used for other uses than constantly fighting disease. Digestion has also been reportedly better. Medical research has shown that silver promotes more rapid healing, with less scar tissue, even in the case of severe burns. Successes have been reported in cases that previously have been given up by established doctors. Colloidal silver is tasteless and won't sting even a baby's eyes, and won't upset your stomach. More Than 650 Diseases Helped? |
The basic guideline that has been recommended for using colloidal silver is that it usually "works" if you can get a high enough concentration to the "affected area". Some will want to experiment with "higher amounts" (such as 8 or more ounces at a time) to find out what it takes to accomplish this. Do not use colloidal silver if you are allergic to contact with silver metals, or if you notice any digestive upset after use. The following is a partial list of the more than 650 diseases that colloidal silver has been reputed to be successful against: acne, AIDS (Reference 8), allergies, appendicitis, arthritis, athlete's foot, bladder inflammation, blood parasites, blood poisoning, boils, burns, cancer (References 2, 4, 7), candida, cholera, colitis, conjunctivitis, cystitis, dermatitis, diabetes (Reference 1), dysentery, eczema, fibrositis, gastritis, gonorrhea, hay fever, herpes, impetigo, indigestion, keratitis, leprosy, leukemia, lupus, lymphangitis, Lyme disease, malaria, meningitis, neurasthenia, parasitic infections: viral, fungal and bacterial pneumonia, pleurisy, prostate, pruritus ani, psoriasis, purulent opthalmia, rhinitis, rheumatism, ringworm, scarlet fever, septic conditions of the eyes, ears, mouth, and throat, seborrhea, septicemia, shingles, skin cancer, staphylococcus and streptococcus infections, stomach flu, syphilis, thyroid, tuberculosis, tonsillitis, toxemia, trachoma, all forms of virus, warts, whooping cough, yeast infection, stomach ulcer, canine parovirus and other veterinary uses, and fungal and viral attacks on plants. Simply spray diluted silver on the leaves and add to the soil. |
Many conditions have
benefited from the use of Colloidal Silver, such as gastritis,
malaria, parasitic infections, psoriasis, eye, ear and
mouth infections, yeast infections, either with internal
or external use. Colloidal Silver has been as well very
successful in veterinary use, for instance the
Many conditions have
benefited from the use of Colloidal Silver, such as gastritis,
malaria, parasitic infections, psoriasis, eye, ear and
mouth infections, yeast infections, either with internal
or external use. Colloidal Silver has been as well very
successful in veterinary use, for instance the dreaded
canine parvo virus. Or you can use a diluted solution either
to spray on plant leaves or to treat the soil. And you
can purify a gallon of water in minutes by adding 1/2 teaspoon
of Colloidal Silver.
dreaded
canine parvo virus. Or you can use a diluted solution either
to spray on plant leaves or to treat the soil. And you
can purify a gallon of water in minutes by adding 1/2 teaspoon
of Colloidal Silver.



 Veterinary and Garden Use
Veterinary and Garden Use 